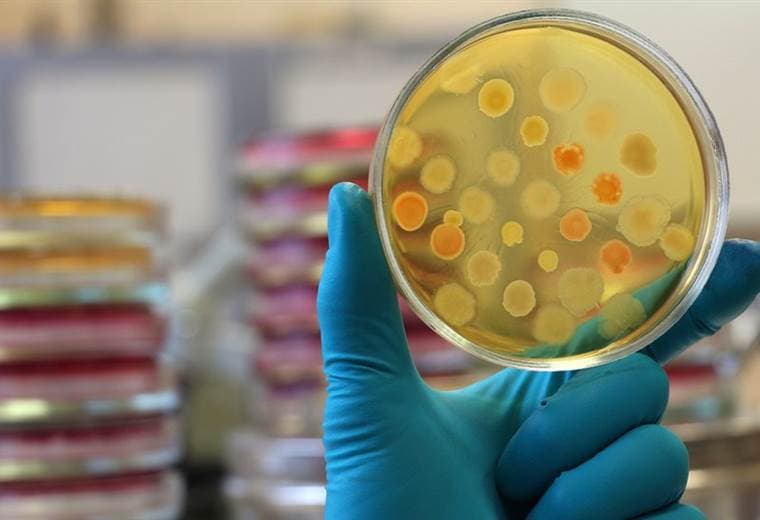
image

Terapia de fagos: Cómo un coctel de virus salvó la vida de mi hija enferma
Una adolescente era víctima de una infección mortal y aparentemente intratable. Los médicos le habían dado menos de un 1% de posibilidad de supervivencia. Pero un cóctel de virus experimental le salvó la vida
El cuerpo de Isabelle estaba siendo atacado por bacterias y los médicos le había dado menos del 1% de posibilidad de supervivencia.
Pero los médicos del Great Ormond Street Hospital de Londres le realizaron una "terapia de fagos" que hasta entonces no había sido probada, y que usa virus para infectar y matar las bacterias.
Y tuvieron éxito.
En la actualidad, Isabelle está saludable, estudiando para sus exámenes escolares y aprendiendo a conducir.
Los expertos dicen que el caso genera un "enorme entusiasmo" ya que el tratamiento con fagos mostró potencial para combatir otras infecciones peligrosas.
¿Qué son los fagos?
Los fagos son la encarnación microbiana del dicho "el enemigo de mi enemigo es mi amigo".
También conocidos como bacteriófagos, son un tipo de virus que infecta las bacterias en lugar de las células del cuerpo.
Como alienígenas malvados, aterrizan en la superficie de una bacteria e inyectan su propio código genético. Esto toma la célula bacteriana y la convierte en una fábrica de fagos hasta que los virus abandonan la célula.
¿Por qué Isabelle los necesitaba?
Isabelle Carnell-Holdaway nació con fibrosis quística, una enfermedad que provoca que se forme mucosidad pegajosa dentro de sus pulmones y que puede albergar infecciones peligrosas.
El Mycobacterium abscessus, de la familia de la tuberculosis, infectó su cuerpo, por lo que necesitaba fuertes antibióticos para mantenerlo bajo control.
A los 16 años fue sometida a un doble trasplante de pulmón, pero las bacterias aún seguían escondidas en su cuerpo.
Cuando comenzó a tomar medicamentos inmunosupresores para evitar que rechazara el trasplante, la infección regresó.
"En nuestra experiencia, cuando vuelve a crecer el Mycobacterium después del trasplante, el paciente muere", dijo Helen Spencer, médica que atiende a Isabelle.
"En algunos pacientes, eso sucede dentro de un año a pesar de ser sometidos a un tratamiento agresivo".
Isabelle tenía grandes lesiones de color negras con signos de putrefacción en su piel donde la infección estaba afianzada.
Terminó en cuidados intensivos cuando su hígado comenzó a fallar y con grandes colonias de bacterias formándose en su cuerpo.
Los médicos dijeron que no podían hacer nada y que Isabelle tenía menos del 1% de posibilidades de supervivencia.
Sus padres decidieron llevarla a su casa donde estaría rodeada de su familia.
¿Cómo surgió la terapia experimental?
La idea de intentar la terapia con fagos vino de la madre de Isabelle, Jo, que había estado investigando alternativas en internet.
El equipo del hospital Great Ormond Street contactó con el profesor Graham Hatfull, del Instituto Médico Howard Hughes, en EE.UU., que tenía la mayor colección de fagos del mundo.
Había alrededor de 15.000 viales de fagos, pero tardaron meses en determinar qué combinación podría funcionar contra la infección de Isabelle.
El equipo de Estados Unidos se centró en tres fagos, dos de los cuales fueron modificados genéticamente para hacerlos más efectivos.
El coctel se inyectó en su torrente sanguíneo dos veces al día y se aplicó directamente en las lesiones en su piel, según un artículo publicado en la revista Nature Medicine.
¿Cuán buenos fueron los resultados?
La madre de Isabelle notó la diferencia en cuestión de semanas. Jo no tiene ninguna duda de que la vida de su hija fue salvada por los virus.
Las lesiones de Isabelle comenzaron a curarse y algunas heridas que habían estado abiertas por meses empezaron a cerrarse.
"Cuando salimos del hospital, ella parecía literalmente un esqueleto con la piel, estaba muy mal", describió Jo a la BBC.
"Fue absolutamente increíble el efecto que el fago tuvo en ella. Isabelle recuperó su propia vida, la vida de una niña de 17 años", añadió.
Regresó a la escuela en septiembre, aprobó exámenes de matemáticas y ahora está estudiando para otras asignaturas. También está aprendiendo a conducir.
"Esto es increíble, aunque aún funciona lentamente. Es genial poder hacer todas estas cosas por mi cuenta sin tener ningún problema", le cuenta Isabelle a la BBC.
¿Está curada?
La infección de Isabelle no está curada completamente, pero está bajo control.
Todavía se inyecta dos cócteles virales todos los días.
Y la familia está esperando que se agregue un cuarto fago a la mezcla en un intento de eliminar por completo la infección.
"Realmente es increíble, pero también está teñido de tristeza cuando pienso en todos los pacientes que no sobrevivieron porque el tratamiento no estaba disponible a tiempo para ellos", analizó la doctora Spencer.
La historia de Isabelle es extraordinaria, pero también se trata de un solo caso.
Técnicamente, los científicos no están seguros de cuán efectivo es el fago porque no han podido realizar ensayos clínicos.
"Tenemos que ser muy cuidadosos al extrapolar un caso individual a otros pacientes y lo que podría significar para ellos", agregó Spencer.
"Pero creo que alienta la futura investigación sobre la terapia con fagos para algunas de esas bacterias resistentes que realmente nos preocupan".
¿Es nueva la terapia con fagos?
La terapia con fagos no es nueva, en medicina se ha estado utilizando durante casi un siglo.
Hubo investigaciones que se desarrollaron en Georgia y otros países en la antigua URSS, pero nunca se convirtió en medicina convencional.
La terapia con fagos fue eclipsada por el descubrimiento de los antibióticos, que son mucho más fáciles de usar.
Un antibiótico puede actuar en una amplia gama de infecciones bacterianas, mientras que la terapia con fagos requiere encontrar cuáles son los que atacarán cada infección.
Pero ahora la terapia con fagos está teniendo un resurgimiento debido al aumento de superbacterias que son resistentes a los antibióticos.
"La idea es usar bacteriófagos como antibióticos, como algo que podríamos usar para matar bacterias que causan infecciones", dijo el profesor Graham Hatfull, del Instituto Médico Howard Hughes.
Aunque advirtió que aún se trata "un territorio inexplorado".
Martha Clokie, profesora e investigadora de fagos en la Universidad de Leicester (Reino Unido) le dijo a la BBC que "los bacteriófagos pueden desarrollarse con éxito como agentes terapéuticos, incluso en circunstancias muy difíciles donde las bacterias son resistentes a muchos antibióticos y son difíciles de tratar".
"Creo que (este caso) allanará el camino para otros estudios de este tipo y ayudará a que se realicen los ensayos necesarios con bacteriófagos para que puedan usarse de una manera más amplia para tratar a los humanos".